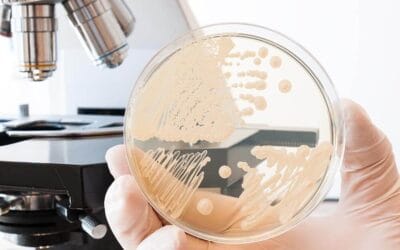
Candida Diet

Morbi pharetra ipsum congue tortor ornare sollicitudin. Fusce rutrum mi nec turpis cursus porta non ac arcu. Aenean at justo sapien. Quisque lacinia arcu eget tellus varius, id luctus ipsum congue.
Candida
Candida Help
Nulla ut urna eu lacus bibendum pellentesque. Pellentesque sodales tincidunt lacus, id lacinia elit efficitur eget. Vivamus molestie mauris eu sem elementum, vitae pellentesque purus varius.
Candida Diet
Diet for Candida If you have been diagnosed with Candida, it is important to manage your diet carefully as Candida feeds off of sugar and yeast. Therefore if you keep on eating sugar and yeast the candida will grow. This article will give the step by step instructions...
Cystitis and Candida
Ut laoreet id ex vitae tempus. Integer tristique mi ipsum. Vestibulum lorem ipsum dolor dui velit, euismod quis tortor vitae, scelerisque dapibus odio. Mauris in enim in velit feugiat interdum eu vel dui.